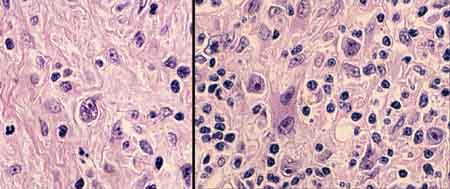

|
|
 Go to: TOC |
 A Reed-Sternberg cell occupies the center, surrounded by not-too-many lymphocytes and fibrosis that might be described as disorganized. When viewed through polarized light, it is not birefringent, unlike the fibrous bands of nodular sclerosis.
Additional cases.
 |